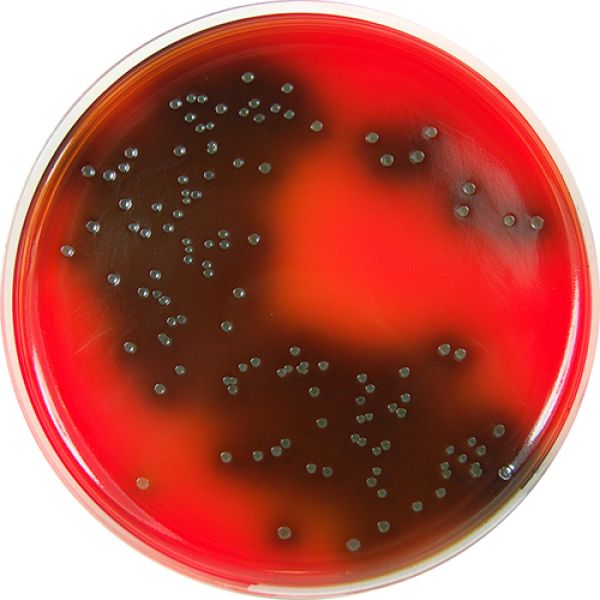

Fraser Broth (acc. to ISO 11290)
- Format: 10 ml x 50 Tubes
- Code: TMB_FB_T10_50
- Technologie: Milieux et tests de confirmation ISO
- Application: Analyses microbiologiques
- Tags / Filtre: Listeria
Les bouillons Fraser sont utilisés pour lenrichissement primaire (Half Fraser) et secondaire (Fraser) dans la détection de Listeria spp. dans les produits alimentaires conformément à la norme ISO11290. Laction combinée du chlorure de lithium, de lacriflavine et de lacide nalidixique, présents dans ces bouillons inhibe la flore concomitante assurant lespace biologique pour la croissance de Listeria. Ces deux bouillons sont légèrement tamponnés afin de ralentir lacidification (flore acidifiante), ce qui inhibe la croissance de Listeria. Après enrichissement (primaire ou secondaire), la présence de Listeria est mise en évidence par un changement de couleur du bouillon qui devient jaune à brun foncé (en raison de lhydrolyse de lesculine présente comme ingrédient). Cependant, ce changement de couleur nest pas systématique et selon la norme ISO11290 il est également essentiel deffectuer une isolation sur un sol sélectif (ALOA, PALCAM et/ou Oxford).
Nous travaillons pour publier de nouveaux documents ici, en attendant, si vous avez besoin de plus d'informations
clicca qui.
Download
Pour afficher le contenu bloqué, veuillez vous connecter ici
 RiboFlow – Test moléculaire rapide pour la recherche et différenciation de Listeria spp. et Listeria monocytogenes – Validé ISO16140
RiboFlow – Test moléculaire rapide pour la recherche et différenciation de Listeria spp. et Listeria monocytogenes – Validé ISO16140
 Kit PolySkope Multiplex qPCR pour Salmonella, Listeria monocytogenes et STEC à détection simultanée certifié AOAC
Kit PolySkope Multiplex qPCR pour Salmonella, Listeria monocytogenes et STEC à détection simultanée certifié AOAC